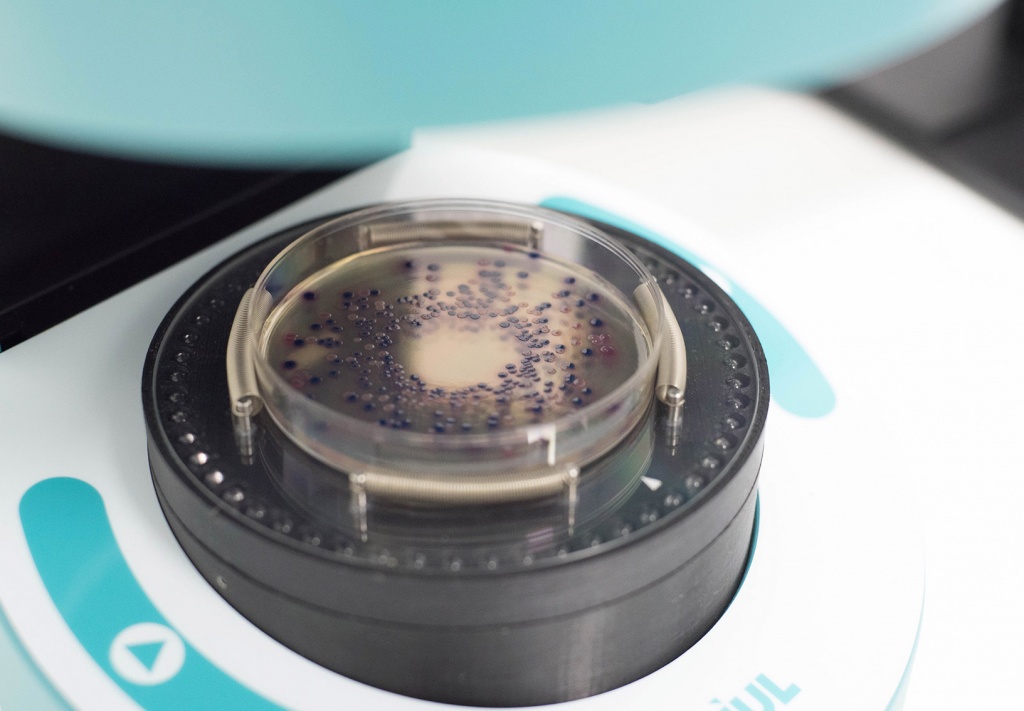
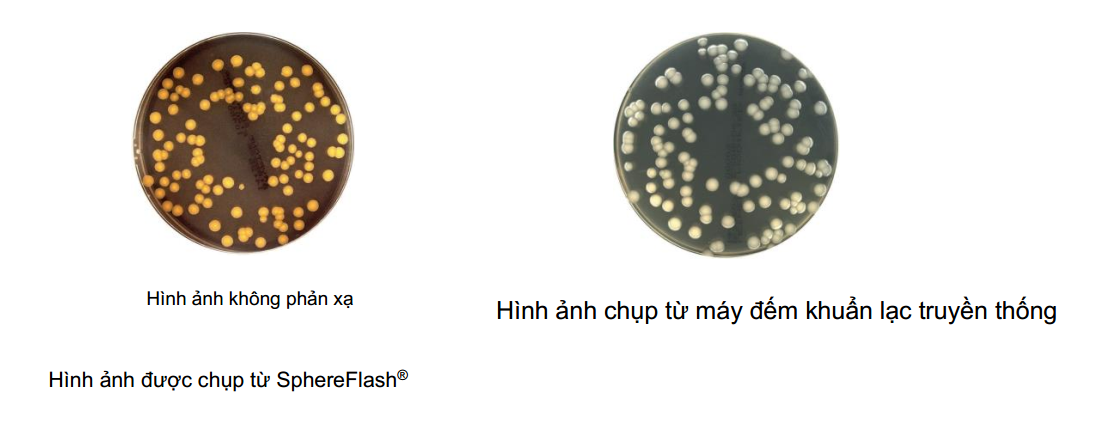

Máy đếm khuẩn lạc tự động và Đo vòng vô khuẩn
Model: SphereFlash®
CAT. 90007000
Hãng: IUL-Tây Ban Nha
Xuất xứ: Tây Ban Nha
Máy đếm khuẩn lạc tự động & Đo vòng vô khuẩn Halos với Phần mềm đẳng cấp thế giới, chiếu sáng đồng đều & không phản xạ

Tổng quan về sản phẩm:
- SphereFlash® là máy đếm khuẩn lạc tự động đáp ứng tất cả các yêu cầu có thể được yêu cầu trong phòng thí nghiệm vi sinh hiện đại.
- Với phiên bản phần mềm Colony Lite, nó thực hiện việc đếm khuẩn lạc một cách đơn giản và đáng tin cậy nhờ phần mềm đẳng cấp thế giới và hệ thống chống sét tích hợp được cấp bằng sáng chế.
- Đối với những người dùng khó tính hơn, phần mềm có thể được nâng cấp lên Colonies PRO để tăng khả năng của nó, ví dụ: cài đặt Cấp độ cấp phép người dùng, kết nối LIMS, Bảng tính, Đọc mã vạch, Báo cáo, lịch sử hoạt động hoặc CFR21 Phần 11.
- Với ứng dụng Halos PRO tùy chọn, máy đếm khuẩn lạc tự động Sphere Flash có thể được chuyển đổi để đo các vòng vô khuẩn chấp nhận các tiêu chí gần đúng vòng tròn khác nhau để có được đường kính tương ứng của các khu vực vòng tròn ảo.
- Trong tất cả các phiên bản, ánh sáng được thực hiện thông qua đèn LED được định hướng vào mặt tường bên trong của buồng hình cầu chuyển động. Kết quả tạo ra ánh sáng đồng nhất tuyệt vời và không phản xạ trong một thiết bị đếm khuẩn lạc.
- Quả cầu chuyển động tự động đóng buồng và ngăn khu vực mà đĩa Petri được đặt từ bất kỳ ánh sáng bên ngoài nào. Nó tránh bất kỳ sự phản xạ hoặc can thiệp của ánh sáng bên ngoài, tạo ra một bầu không gian ánh sáng mà không có sự phản chiếu của các mặt từ đĩa Petri hoặc của các khuẩn lạc.
- Đối với phương tiện truyền ánh sáng trong suốt bằng cách truyền này cũng có sẵn trong tất cả các phiên bản.
Những lợi ích chính:
- Phần mềm đẳng cấp thế giới: Dễ dàng sử dụng & trực quan nhưng là một phần mềm mạnh mẽ. Ngay cả trong phiên bản LITE, nó sẽ phát hiện một loạt nhiều loại vi khuẩn với số lượng nhỏ hoặc không có.
- Chiếu sáng không phản xạ: Buồng hình cầu được cấp bằng sáng chế loại bỏ các phản xạ ở cả khuẩn lạc và đĩa Petri, và cung cấp ánh sáng đơn sắc để hình ảnh chụp được cải thiện cho kết quả tốt hơn, đáng tin cậy hơn và phù hợp hơn.
- Vòng tròn kiểm tra: Bộ hồ sơ theo thời gian liên quan đến bảo mật sẽ cung cấp bằng chứng tài liệu về chuỗi các hoạt động đã bị ảnh hưởng bất cứ lúc nào một hoạt động hoặc sự kiện cụ thể trong SphereFlash®.
- Tạo báo cáo: Tạo báo cáo kết quả dễ dàng và tự động với bố cục có thể tùy chỉnh bao gồm logo và / hoặc thông tin của Công ty.
- Khả năng mở rộng: Bắt đầu phiên bản phần mềm LITE của Khuẩn lạc (bao gồm đơn vị), nó có thể được nâng cấp độc lập lên Colonies PRO hoặc Halos PRO.

- Phương pháp mới: Một phần mềm xử lý hình ảnh nhanh và mạnh mẽ cùng với việc đóng buồng hình cầu tự động cho phép người dùng can thiệp nhỏ và tối ưu hóa thời gian. Một lượng lớn các đĩa có thể được đếm chính xác.
Thông số kỹ thuật:
- Đĩa Petri đường kính tối đa có thể sử dụng: 90mm
- Giao diện máy tính: USB 3.0 Type-A socket
- Đầu ra bộ nguồn AC: 12V DC 3.43A
- Thang công suất: 90~264 VAC
- Dải tần số: 47~63Hz
- Công suất lớn nhất: 40W
- Cấp quá áp: II
- Nhiệt độ không khí 15-30ºC (59-86ºF)
- Độ ẩm tương đối : 10-75% (không ngưng tụ).
- Độ cao: Lên đến 2000m (6500ft)
- Nơi hoạt động: Chỉ sử dụng trong nhà.
- Dải tần số: 50-60Hz
- Mức độ ô nhiễm: 2
- Kích thước: 288x220x371 mm (1.34x8.66x14.6 in).
- Trọng lượng: 5,5Kg (12,13 lb).
Yêu cầu máy tính:
- Hệ điều hành Windows® 7, 8.1,10 (x64 platforms).
- Cổng USB 3.0 .
- Bộ nhớ RAM 8 GB..
- 100 Megabyte dung lượng đĩa trống và 100 Gigabyte cho Cơ sở dữ liệu (cho 5000 kết quả được lưu trữ với hình ảnh).
- Nên sử dụng màn hình Full HD (1920x1080px).
- Khuyến nghị kích thước màn hình.24’’.
- Microsoft Excel® 2007 trở lên, 64 bit để mở tệp Excel® đã xuất.
- Một máy in PDF ảo để tạo báo cáo PDF.
Thông tin đặt hàng:
- Máy đếm khuẩn lạc SphereFlash®. (Bao gồm phần mềm khuẩn lạc LITE ) CAT. 90007000
- Phần mềm khuẩn lạc PRO CAT. 90007001
- Phần mềm Halos PRO CAT. 90007002
------------------------------------------------------------------------------------------------------------
Đại diện nhập khẩu và phân phối thiết bị Vi sinh IUL-Tây Ban Nha tại Việ t Nam


Hotline: Mr.Hoang – 091.880.4433
Email: Hoang.tbviethoang@gmail.com
Hân hạnh được phục vụ quý khách hàng trong những dự án sắp tới!